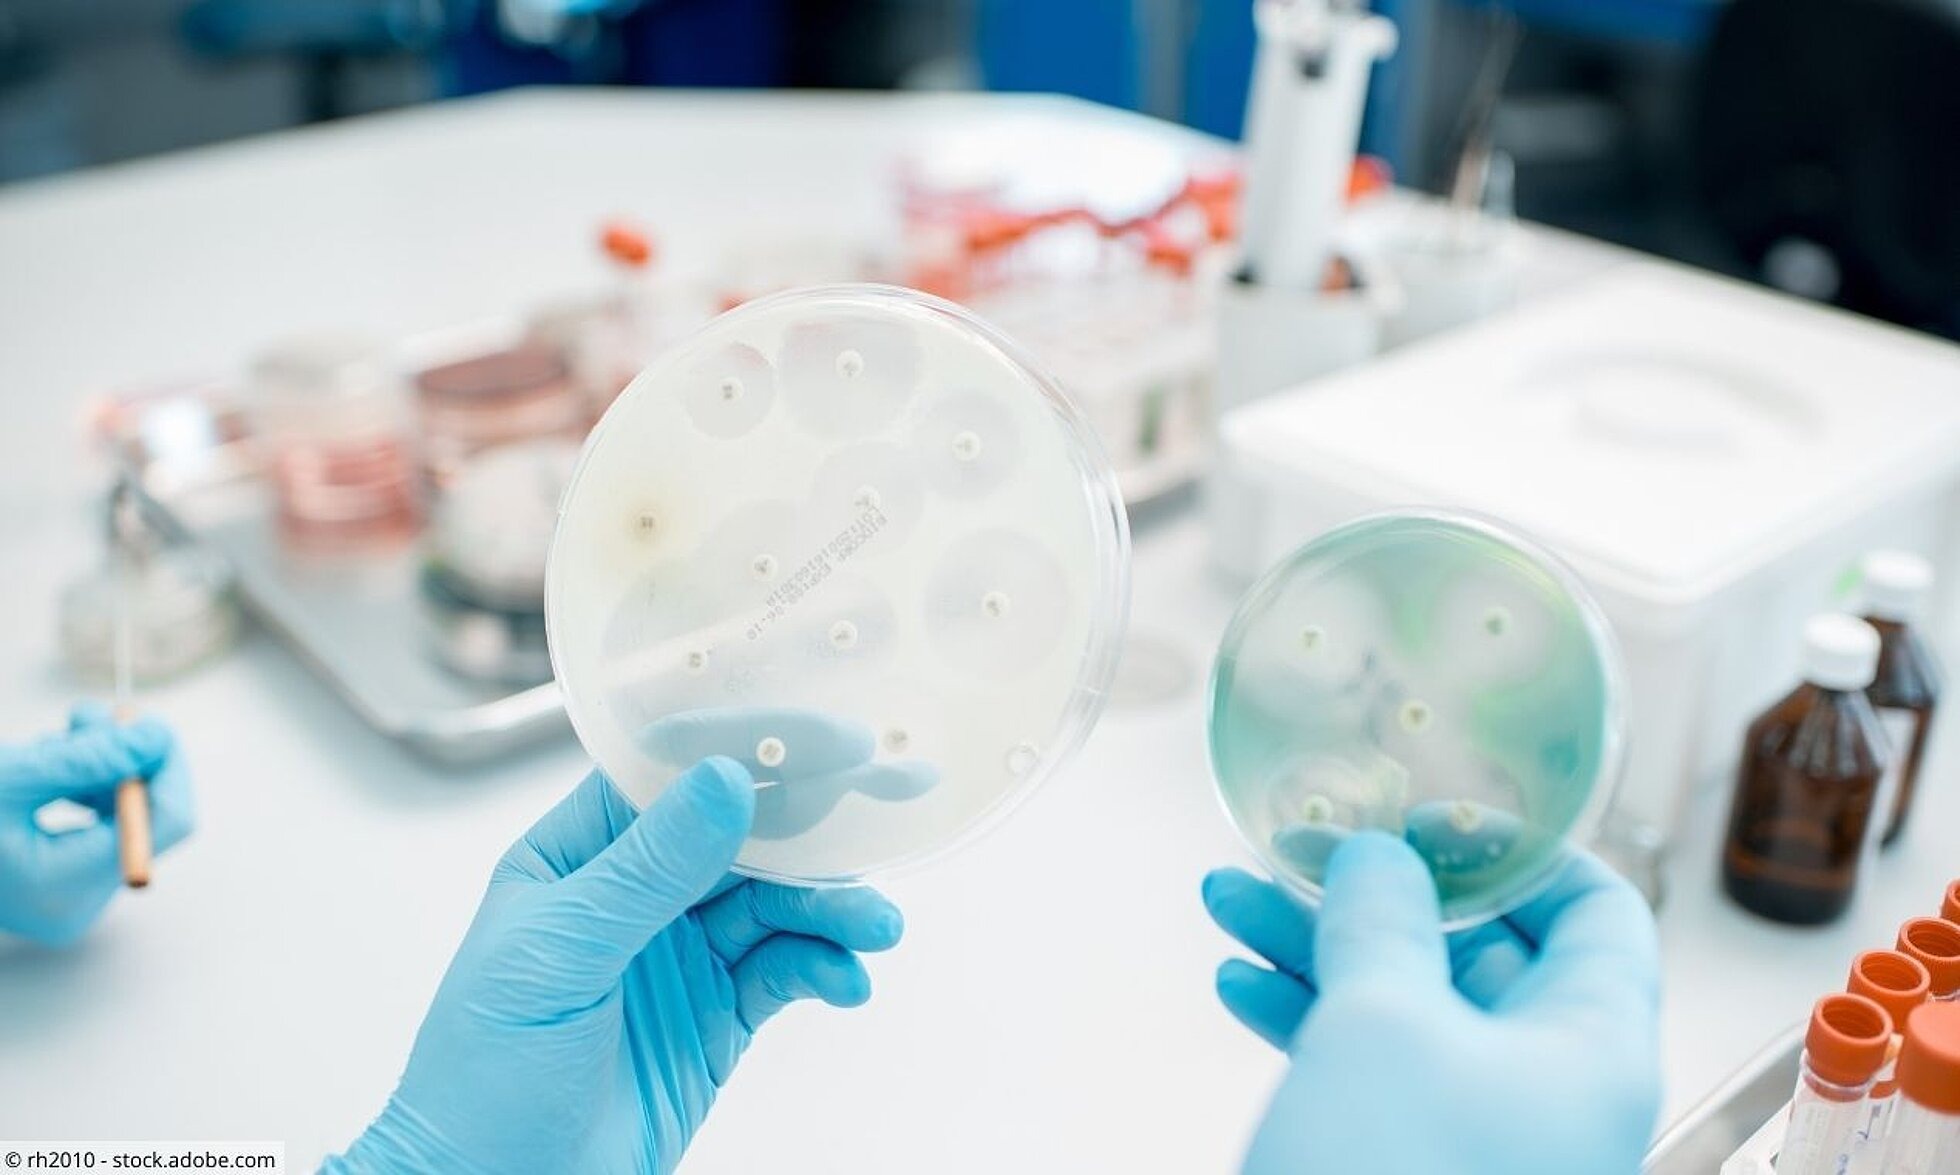

Grundsätzlich ist es wichtig, dass Antibiotika niemals nur auf Verdacht eingenommen werden sollten. Infekte müssen immer ärztlich abgeklärt werden. Denn gerade, weil Antibiotika so wirkungsvoll sind, steht ein sorgsamer Umgang mit ihnen an erster Stelle. Eine unbedachte oder fehlerhafte Einnahme kann dazu führen, dass die Wirksamkeit dieser Arzneimittel abnimmt. Die zunehmende Widerstandsfähigkeit (Resistenz) vieler bakterieller Erreger gegenüber Antibiotika kann schon seit Jahren beobachtet werden. Krankheiten, die zuvor gut therapierbar waren, können dadurch immer schlechter behandelt werden.
Was ist eine Antibiotikaresistenz?
Der Begriff „Resistenz“ bedeutet „Widerstand“. In der Medizin werden beispielsweise Bakterien als resistent bezeichnet, wenn sie gegenüber äußeren Einflüssen - speziell gegenüber Antibiotika - widerstandsfähig sind.
Problematisch ist diese Widerstandsfähigkeit deswegen, weil viele Antibiotika gegen bakterielle Erreger keine Wirkung mehr zeigen, sie sind resistent und sichern so ihr Überleben. Antibiotikaresistente Krankheitserreger entstehen entweder durch spontane Veränderungen im Erbgut oder durch den Austausch von Genen. Die veränderte genetische Information und somit auch die Resistenz können damit auf andere Bakterien übertragen werden. Kritisch wird es dann, wenn diese widerstandsfähigen Bakterien nicht nur gegen ein Antibiotikum, sondern gegen mehrere Antibiotika unempfindlich werden. Es entsteht eine sogenannte Multiresistenz.
Ursachen einer Antibiotikaresistenz
Ursache für Resistenzen ist häufig der sorglose Umgang mit Antibiotika. Die Patientin oder der Patient hält sich nicht an die Einnahmevorschriften beispielsweise bei der Wechselwirkung mit Lebensmitteln oder nimmt die Antibiotika unregelmäßig oder zu kurz ein. Dadurch begünstigt man die Entstehung widerstandsfähiger Bakterien. Diese überleben und sind gegen den Wirkstoff unempfindlich.
Gerade bei Antibiotika ist es wichtig, sie nach Vorschrift der Ärztin bzw. des Arztes einzunehmen:
- in der vorgeschriebenen Dosierung
- im richtigen zeitlichen Abstand
- über den festgelegten Behandlungszeitraum.
Auch der unkritische Einsatz von Antibiotika bei Krankheiten, bei denen die Anwendung eher nicht sinnvoll ist, kann eine Resistenz begünstigen. So werden Antibiotika häufig bei unkomplizierten Erkältungskrankheiten eingesetzt, obwohl hinter dem Infekt oft Viren stecken. Antibiotika sind jedoch unwirksam gegen Viren. Der Einsatz von sogenannten Breitspektrum-Antibiotika, die gegen viele bakterielle Krankheitserreger eingesetzt werden können, fördert ebenfalls die Resistenzbildung. Schmalspektrum-Antibiotika wären hingegen in manchen Fällen ausreichend, da sie zwar nur gegen eine bestimmte Bakterienart wirksam sind. Diese bekämpfen sie aber gezielt. Blut-, Urin- oder Speichelproben können Aufschluss darüber geben, ob Viren oder Bakterien für die Infektion verantwortlich sind und ob bzw. welches das geeignete Antibiotikum ist.
Folgen einer Antibiotikaresistenz
Gerade für ältere Menschen, chronisch kranke Personen sowie für kleinere Kinder können Resistenzen gegen Antibiotika ernstzunehmende Folgen haben. Infektionen können länger andauern und die medikamentöse Therapie gestaltet sich schwieriger. Im schlimmsten Fall können eigentlich gut behandelbare bakterielle Erkrankungen lebensbedrohlich werden. Inzwischen gibt es Infektionen, für die kaum noch wirksame Antibiotika zur Verfügung stehen. Sogenannte Reserve-Antibiotika müssen dann zum Einsatz kommen, die ihrerseits mehr Nebenwirkungen haben.
(Multi-)Resistente Erreger
Sogenannte „Streptokokken“ und „Staphylokokken“ gehören zu den häufigsten Vertretern der resistenten Keime. Darunter ist auch der „Methicillin-resistente Staphylococcus aureus“, kurz MRSA. Das Risiko für eine MRSA-Infektion ist bei gesunden Menschen sehr gering.
Vorkommen und Übertragung von multiresistenten Erregern
Krankenhäuser sind die Orte, in denen solche multiresistenten Erreger (MRE) besonders häufig entstehen, da dort unterschiedliche Krankheitserreger vorkommen, die mit verschiedenen Antibiotika behandelt werden müssen. Gerade Patientinnen und Patienten, die lange Krankenhausaufenthalte haben und mit Antibiotika behandelt werden müssen, sind besonders gefährdet.
Es gibt unterschiedliche Wege, wie multiresistente Erreger zwischen Menschen übertragen werden können:
- direkter Kontakt, beispielweise über die Hände: Dabei ist entscheidend, dass es sich um häufigen, engen und intensiven Hautkontakt handelt.
- über Tröpfchen, beispielsweise durch Husten, Niesen oder Sprechen: Dabei werden Keime direkt über die Luft verbreitet.
Auf Intensivstationen ist das Risiko besonders hoch. Auch bei noch so strikter und gewissenhafter Hygiene können durch Magensonden, Blasenkatheter oder Infusionen Erreger eindringen und lebensbedrohlich werden. Die sorgfältige Einhaltung von Hygienemaßnahmen in Krankenhäusern ist daher besonders wichtig, auch zum Schutz vor Resistenzentwicklung. Gleiches gilt auch für Alten- und Pflegeheime.
Der richtige Umgang mit multiresistenten Erregern
Im Krankenhaus sollen sehr streng einzuhaltende Hygienemaßnahmen dafür sorgen, dass MRE nicht auf andere übertragen werden. Dennoch können sich Erreger zum Beispiel auf der Haut einer Person anhäufen, ohne dass diese unmittelbar erkrankt. Man spricht von einer besiedelten Person. Wird eine besiedelte Person entlassen, stellt sich häufig die Frage, wie mit dieser Tatsache umgegangen werden sollte. Schließlich lässt sich eine Übertragung auf andere Menschen nicht immer vermeiden. Während die MRE keine Gefahr für gesunde Menschen darstellen sollten, gilt es vornehmlich, die besiedelte Person vor Infektionen zu schützen.
Verhalten im Alltag
- Generell gilt, dass sich die Überlebensfähigkeit dieser Keime auf sauberen und trockenen Oberflächen verringert. Reinigen Sie deshalb die Flächen mit handelsüblichen Reinigungsmitteln. Eine Desinfektion ist nur bei sichtbaren Verschmutzungen beispielsweise mit Blut oder Stuhl erforderlich.
- Waschen Sie die Kleidung bei mindestens 60 °C.
- Nach direktem Kontakt mit Blut oder Stuhl desinfizieren Sie bitte gründlich Ihre Hände.
- Körperpflegegegenstände (Handtücher, Seife, Rasierer) dürfen nicht gemeinsam benutzt werden.
- Verwenden Sie Flüssigseife statt Stückseife.
- Während der Behandlung sollte die besiedelte Person neben der speziell verordneten Waschlotion und Nasensalbe auch Deospray statt eines Deorollers und Lotionen und Cremes aus Tuben statt aus Tiegeln verwenden.
- Eine gesunde und natürliche (Schleim-) Hautflora ist von großer Bedeutung! Um diese zu erhalten, ist normales Waschen bzw. Duschen ausreichend. Ein Zuviel (Waschen, Desinfizieren) schadet eher als es nützt.
- Schwangere Frauen zählen grundsätzlich nicht zu den Risikogruppen. Dennoch sollte in den letzten Wochen vor der Entbindung, vor einem absehbaren Kaiserschnitt oder während des Wochenbetts bei Besuchen von besiedelten Personen Rücksprache mit dem Arzt bzw. der Ärztin gehalten werden.
- Achten Sie auf eine sorgsame Händehygiene vor der Verarbeitung von Lebensmitteln sowie auf eine getrennte Aufbewahrung von Fleisch, Geflügel und Meeresfrüchten von anderen Lebensmitteln. Waschen Sie Ihre Hände nach jedem Zubereitungsschritt und verwenden Sie unterschiedliche Küchengegenstände (Schneidebretter, Messer), wenn es um die Zubereitung von Fleisch, Fisch und Gemüse geht. Gemüse und Salat sollten grundsätzlich vor dem Verzehr gewaschen werden.